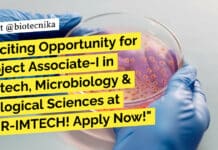
Exciting Opportunity for Project Associate-I in Biotech, Microbiology & Biological Sciences at CSIR-IMTECH! Apply Now! CSIR-IMTECH Hiring Project Associate - Biotech, Microbiology & Biological Sciences

Exciting Opportunity for Project Associate-I in Biotech, Microbiology & Biological Sciences at CSIR-IMTECH! Apply...
CSIR-IMTECH Hiring Project Associate - Biotech, Microbiology & Biological Sciences
Rolling Advt. No. 09-07
Company Overview:
CSIR-IMTECH (Institute of Microbial Technology), a constituent laboratory of the Council...
Breaking: DIAGEO is Hiring a Food Tech & Microbiology Quality Executive in Aurangabad! Find...
Quality Executive Job at DIAGEO - Food Tech & Microbiology Apply
Food Tech & Microbiology Quality Executive Job at DIAGEO
Job Posting: Senior Executive - Quality
Location:...
Unleash Your Discovery Biology Potential: Join Vipragen Biosciences as a Senior Research Scientist and...
Exciting Opportunity Alert!!!!
Looking for: Sr. Research Scientist - Discovery Biology - In Vitro at Vipragen Biosciences!
Qualification Requirements:
MS degree with 6+ years of research...
Discover the Exciting Role of an Associate QC Specialist for Life Sciences at Novartis...
Associate QC Specialist For Life Sciences at Novartis India
About Novartis:
Novartis is a global healthcare company that provides solutions to address the evolving needs of...
Calling all Bioinformatics Engineers! Join our team and revolutionize data-driven healthcare!
Strand Life Sciences Bioinformatics Engineer Job - Apply Now
WE ARE HIRING!
JOIN OUR TEAM
Bioinformatics Engineer
Seeking a motivated Bioinformatics Engineer with 3-8 years
of experience in bioinformatics...
Unlock the Secrets of Product Placement in the World of Vegetable Crops at Syngenta...
Product Placement Scientist at Syngenta
Company Description
Syngenta Seeds is one of the world’s largest developers and producers of seed for farmers, commercial growers, retailers, and...
Get Hired at MSN Labs – High-Paying Biotech QA Job Position Available Now!
MSN Labs Biotech QA Job Position
We are a leading biotech company, MSN Labs, specializing in the development and production of pharmaceutical products. We are...
Apply for a Junior Research Fellow (JRF) position in DRDO Funded Project – Biotechnology,...
JRF Job at Pachhunga University College - Applications Invited
DEPARTMENT OF BIOTECHNOLOGY
Pachhunga University College
(A CONSTITUENT COLLEGE OF MIZORAM UNIVERSITY)
AIZAWL -796001: MIZORAM, INDIA
(NAAC A+ Institute, UGC-...
URGENT: High-Paying Food Chemist Job – Join a Leading Global Company Now!
Bureau Veritas India Food Chemist Job - Attend Walk-In
Urgent Vacancy: Food Chemist
Bureau Veritas India Pvt Ltd is a leading global testing, inspection, and certification...
Breaking News: Reliance Industries Hiring Research Scientist in Biology! Apply Now!
Research Scientist Job at Reliance Industries For Biology
About the Company:
Reliance Industries is a leading multinational conglomerate company with businesses across various industries, including oil...
Multiple Vacancies at Gujarat Biotechnology Research Centre for Life Science Candidates
Multiple Vacancies at GBRC!
Gujarat Biotechnology Research Centre (GBRC) invites applications from the interested deserving candidate for the post of PS III (01), PAI (01),...
Unleash Your Nutrition Potential: Land an Internship at PATH in Food Tech & Food...
Food Tech Internship - Food Science Internship, Apply Online
Food Tech & Food Science Intern Opportunity at Path
Company Description
PATH is a global nonprofit dedicated to...
Don’t Miss Out on the Ultimate Biotech Career Opportunity! Apply Now for the Industrial...
GSBTM Biotech Training Program 2023-24 - Industrial Biotech Training
Industrial Biotech Training Program (IBTP) 2023-24
About Us
Gujarat State Biotechnology Mission (GSBTM) is dedicated to advancing the...
Exciting Opportunity: Join the Cutting-Edge Nanobiotechnology Lab at MIT and Kickstart Your Engineering Career...
Life Sciences Job MIT School of Bioengineering Sciences & Research
MIT School of Bioengineering Sciences & Research
At MIT School of Bioengineering Sciences & Research, we...
Alarming News for Health: India’s Last-Resort Antibiotics Losing Effectiveness!
Last-Resort Antibiotics Losing Effectiveness in India - Alarming News
A new report from the Indian Council of Medical Research (ICMR) reveals that the antibiotics we...